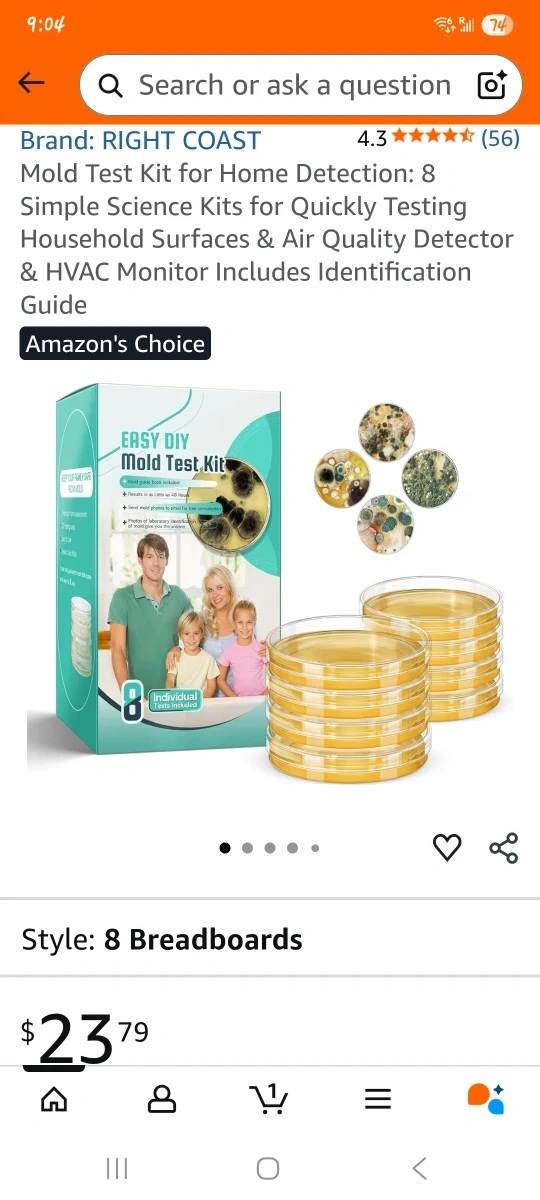

Mold Test Kit for Home Detection
$20
I'm selling a RIGHT COAST Mold Test Kit for Home Detection. It includes 8 Simple Science Kits for Quickly Testing Household Surfaces & Air Quality Detector & HVAC Monitor. It also includes an Identification Guide.
- ConditionNew
0 chats0 favorites3 views


